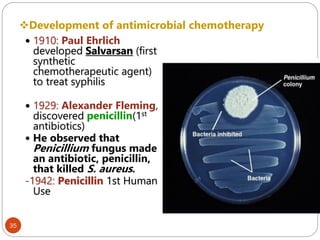
Development of antimicrobial chemotherapy
35
 1910: Paul Ehrlich
developed Salvarsan (first
synthetic
chemotherapeutic agent)
to treat syphilis
 1929: Alexander Fleming,
discovered penicillin(1st
antibiotics)
 He observed that
Penicillium fungus made
an antibiotic, penicillin,
that killed S. aureus.
-1942: Penicillin 1st Human
Use
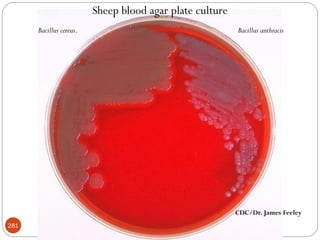
CDC/Dr. James Feeley
Sheep blood agar plate culture
Bacillus anthracis
Bacillus cereus.
281
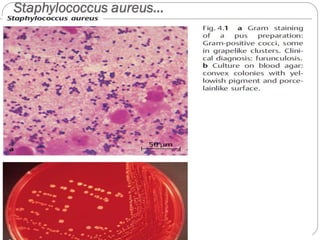
Staphylococcus aureus…
343
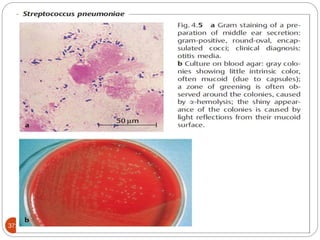
371

The document provides an extensive overview of microbiology, including its definition, branches, importance, and history, particularly focusing on the development of medical microbiology. It highlights discoveries by key figures like Anton van Leeuwenhoek, Louis Pasteur, and Robert Koch, explaining theories such as spontaneous generation and biogenesis, as well as Koch's postulates for establishing disease causation. The text also discusses beneficial roles of microorganisms in various applications, such as food production and environmental processes, alongside their potential negative impacts on health.

![47
serologic reactions - antigen-antibody reactions
protein types - determined by polyacrylamide gel
electrophoresis [ PAGE ]
phage typing - using bacteriophages to identify
bacterial strains
DNA hybridization - to determine closeness of
relationship between various bacteria
base sequence of nucleic acids (DNA & rRNA)](https://image.slidesharecdn.com/microfornur-240420024007-475abfaf/85/MICRO-FOR-NUR-pdf-microbiology-only-for-47-320.jpg)


















































































































![162
Most hospitals aim surveillance for infections
With a high level of morbidity [e.g., intensive care unit
(ICU)–related infections and nosocomial pneumonia];
costly (e.g., cardiac surgical wound infections);
difficult to treat (e.g., infections due to antibiotic-resistant
bacteria)
pose recurrent epidemic problems (e.g., Clostridium
difficile–related diarrhea); and
potentially preventable (e.g., vascular access–related
infections).](https://image.slidesharecdn.com/microfornur-240420024007-475abfaf/85/MICRO-FOR-NUR-pdf-microbiology-only-for-162-320.jpg)